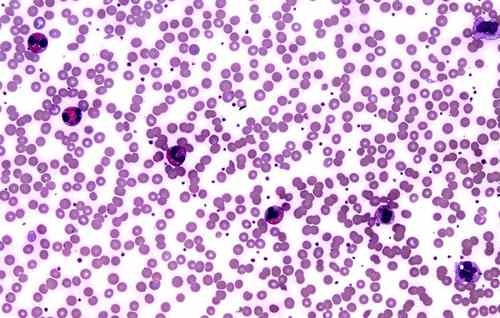

Šta je eozinofilija? Eozinofilija je veći od normalnog nivoa eozinofila. Eozinofili su vrsta belih krvnih zrnaca za borbu protiv bolesti.
Možete imati visok nivo eozinofila u krvi (eozinofilija krvi). Visok nivo eozinofila može se pojaviti u tkivima vašeg tela na mestu infekcije ili zapaljenja (eozinofilija tkiva).
Eozinofilija tkiva se može naći u uzorcima tokom istraživačkog postupka ili u uzorcima određenih tečnosti, poput sluzi oslobođene iz nazalnih tkiva. Ako imate eozinofiliju tkiva, nivo eozinofila u krvotoku je verovatno normalan.
Eozinofilija krvi se može detektovati sa testom krvi, obično kao deo krvne slike. Iznos od više od 500 eozinofila na mikrolitar krvi se obično smatra eozinofilijom kod odraslih. Iznos od više od 1.500 eozinofila na mikrolitar krvi, koji traje nekoliko meseci se zove hipereozinofilni sindrom.
Uzrok
Eozinofilija se javlja kada se veliki broj eozinofila regrutuje na određenu lokaciju u vašem telu ili kada koštana srž proizvodi previše eozinofila. Ovo može biti izazvano različitim uslovima, bolestima i faktorima. Eozinofilija može biti idiopatska (primarna) ili, češće, sekundarna – povezana sa drugom bolešću.
Eozinofilija – uzrok:
– Parazitske i gljivične bolesti
– Alergije (uključujući na lekove ili hranu)
– Uslovi vezani za nadbubrežne žlezde
– Poremećaji kože
– Otrovi
– Autoimune bolesti
– Endokrini poremećaji
– Tumori.
Specifične bolesti i stanja koja mogu rezultirati eozinofilijom krvi ili tkiva uključuju:
– Askarijaza (infekcija glistama)
– Astma
– Atopični dermatitis (ekcem)
– Hronična mijeloidna leukemija
– Kronova bolest
– Alergija na lekove
– Eozinofilna leukemija
– Polenska groznica
– Hočkinov limfom
– Idiopatski hipereozinofilni sindrom (izuzetno visok iznos eozinofila nepoznatog porekla)
– Lupus
– Limfna filarijaza (parazitska infekcija)
– Ostale vrste raka
– Druge parazitske infekcije
– Rak jajnika
– Primarna imunodeficijencija
– Trihineloza
– Ulcerativni kolitis.
Parazitske bolesti i alergijske reakcije na lekove su među najčešćim uzrocima eozinofilija. Hipereozinofilni sindrom teži da ima nepoznat uzrok ili proizilazi iz određenih vrsta raka, kao što su rak koštane srži ili limfnih čvorova.
Eozinofili
Eozinofilni granulociti, obično se nazivaju eozinofili (ili, ređe, acidofili ) su vrsta belih krvnih zrnaca (leukocita) i jedna od komponenti imunog sistema, koja je odgovorna za borbu protiv višećelijskih parazita i određene infekcije. Uz mastocite, oni takođe kontrolišu mehanizme povezane sa alergijom i astmom. Oni su granulociti koji se razvijaju tokom hematopoeze u koštanoj srži pre migriranja u krv.
Dakle, najjednostavnije rečeno, eozinofili su vrsta belih krvnih zrnaca za borbu protiv bolesti.
Eozinofili igraju dvostruku ulogu u vašem imunom sistemu:
– Uništavanje stranih supstanci. Eozinofili mogu konzumirati strane supstance – posebno supstance koje se odnose na infekciju sa parazitom – koji su “označeni zastavicom” za uništenje drugim komponentama imunog sistema.
Regulisanje upale. Eozinofili pomažu u promovisanju upale, što igra povoljnu ulogu u izolaciju i kontroli mesta bolesti. Ali, ponekad zapaljenje može biti veće nego što je potrebno, što može dovesti do problematičnih simptoma ili čak oštećenja tkiva. Na primer, eozinofili igraju ključnu ulogu u simptomima astme i alergija, kao što je polenska groznica. Drugi poremećaji imunog sistema takođe mogu da doprinesu hroničnoj upali.
Eozinofilija simptomi
Simptomi eozinofilije su povezani sa osnovnim stanjem koje je uzrokovalo ovaj poremećaj. Na primer, eozinofilija zbog astme je obeležena simptomima poput šištanja i otežanog disanja, dok parazitske infekcije mogu dovesti do bola u stomaku, dijareje, povišene temperature ili kašlja i osipa.
Ako je uzrok eozinofilije reakcija na lek, ovde često dolazi do osipa na koži, a često se simptomi javljaju nakon uzimanja novog leka.
Ređi simptomi eozinofilije mogu uključivati gubitak težine, noćno znojenje, uvećanje limfnih čvorova, drugi osip na koži i ukočenost i peckanje usled oštećenja nerava.
Hipereozinofilni sindrom je stanje gde postoji očigledan razlog za eozinofiliju.
Ovaj redak uslov može uticati na srce, rezultira srčanom insuficijencijom sa kratkim dahom i otokom skočnog zgloba, izaziva uvećanje jetre i slezine, što rezultira otokom stomaka i dovodi do osipa na koži.
Eozinofilija kod dece
Eozinofilija kod dece je najčešće uzrokovana alergijama, imunološkim problemima ili parazitskim infekcijama.
Eozinofilija kod dece – najčešći mogući uzroci uključuju:
1) Alergijske bolesti:
- astma
- sezonski ili hronični rinitis
- urtikarija
2) Dermatološke bolesti:
- atopijski dermatitis
- pemfigus
- dermatitis herpetiformis
3) Parazitske bolesti:
- askarijaza
- amebijaza
- filarioza
- šuga
- šistosomijaza
- toksoplazmoza
- trihinoza.
Postoji još sijaset drugih mogućih uzroka, koje smo naveli na početku ovog članka (uzroci eozinofilije).
Lečenje
Lečenje eozinofilije je usmereno ka osnovnom uzroku ovog poremećaja. Međutim, kod primarne eozinofilije (gde nije uključena druga bolest u organizmu), ili ako iznos eozinofila mora biti smanjen, kortikosteroidi poput prednizona se mogu koristiti. Međutim, imuno-supresija, mehanizam delovanja kortikosteroida, mogu biti fatalni kod pacijenata sa parazitozama.
Poremećaji vezivnog tkiva i alergije, mogu se tretirati sa kortikosteroidima. Parazitske i gljivične infekcije mogu biti pogoršane ili distribuirane sa upotrebom steroida i zato ove lekove treba isključiti u ovom slučaju!
Kod primarne eozinofilije, ne mora biti neophodan tretman. Sve zavisi od stanja pacijenta.